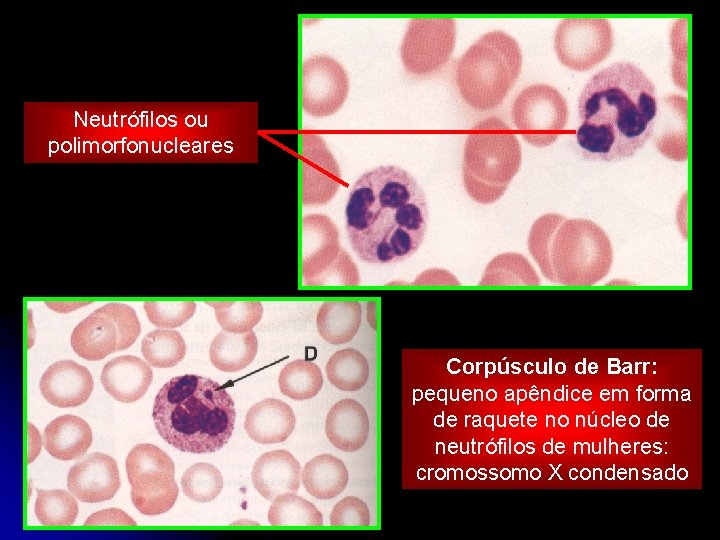
Neutrófilos ou polimorfonucleares Corpúsculo de Barr: pequeno apêndice em forma de raquete no núcleo

CLULAS DO SANGUE E HEMATOPOIESE Prof Sstenes Tecidos

- Slides: 63
CÉLULAS DO SANGUE E HEMATOPOIESE Prof. Sóstenes
Tecidos Hematopoiéticos • Mielóide: Produz quase todas as células sanguíneas sendo encontrada na medula óssea vermelha.
MEDULA ÓSSEA VERMELHA Crânio Esterno Clavícula Costelas Fêmur Tíbia
MEDULA ÓSSEA VERMELHA üCordões de hematopoiese (4 linhagens) ERITROPOESE GRANULOCITOPOESE AGRANULOCITOPOESE PLAQUETOPOESE
Tecidos Hematopoiéticos • Linfóide: Produz e/ou origina linfócitos sendo encontrada em regiões como timo, linfonodos (gânglios), baço e tonsilas (amídalas).
DIFERENCIAÇÃO 1. Céls. Tronco Potencialidade 2. Céls. Progenitoras Mitose Autorenovação 4. Céls. Maduras Atividade funcional diferenciada 3. Céls. Precursoras Influência dos fatores de crescimento
GLÓBULOS SANGUÍNEOS INTRODUÇÃO COMPONENTES HEMATÓCRITO, ESFREGAÇO SANGUÍNEO PLASMA GLÓBULOS VERMELHOS OU ERITRÓCITOS GLÓBULOS BRANCOS OU LEUCÓCITOS
COMPOSIÇÃO SANGUÍNEA HEMATÓCRITO (células) + Plasma Soro Plaquetas 1% 35 -50%
SANGUE – FUNÇÕES GERAIS ü TRANSPORTE - Nutrientes e gases - Produtos do metabolismo - Excretas (uréia, CO 2. . . ) - Hormônios e outras moléculas sinalizadoras - Eletrólitos (sais) ü Regulação térmica ü Defesa Imunológica
SANGUE – FUNÇÕES GERAIS ü Defesa imunológica (LEUCÓCITOS) Toxinas / patógenos /. . . s Fonte de quimiotaxia
Diapedese É a migração de células do sangue para o TCPD para combater um foco infeccioso atraídos por uma FONTE DE QUIMIOTAXIA.
COMPOSIÇÃO SANGUÍNEA (PLASMA) • Água e sais Albumina: pressão osmótica • Proteínas Globulina: anticorpo Fibrinogênio: coagulação Lipoproteínas: HDL, LDL. . .
COMPOSIÇÃO SANGUÍNEA (CÉLULAS) CÉLULAS VERMELHAS + CÉLULAS BRANCAS HEMÁCIAS ERITRÓCITOS PLAQUETAS LEUCÓCITOS GRANULÓCITOS AGRANULÓCITOS
HEMATÓCRITO, ESFREGAÇO SANGUÍNEO INTRODUÇÃO CONSTITUINTES PLASMA GLÓBULOS VERMELHOS OU ERITRÓCITOS GLÓBULOS BRANCOS OU LEUCÓCITOS
ESTUDO HISTOLÓGICO DAS CÉLULAS SANGUÍNEAS Esfregaço histológico
Células vermelhas/Hemácias/Eritrócitos RETICULÓCITOS Ocorrência: • Homem: 5. 200. 000/mm 3 • Mulher: 4. 700. 000/mm 3 ERITRÓCITOS (HEMÁCIAS)
ERITRÓCITOS l l Com hemoglobina (Proteína 4ª com ferro) Transporte de gases Adultas de mamíferos ANUCLEADAS 120 dias de vida (hematocaterese no baço e Hb fagocitada no fígado por céls de Kupfer liberando íons férricos no sangue armazenados na ferritina) Produção constante pela medula óssea vermelha l Discos bicôncavos (↑superfície de Contato e absorção) l
ERITRÓCITOS üFUNÇÃO: Transporte de O 2 e CO 2 (HEMOGLOBINA) • Hb A 1 (97%) - Adulta • Hb A 2 (2%) - Adulta • Hb F (1%) - Fetal Oxi-hemoglobina Carboxi-hemoglobina
Grau de Afinidade da Hb
ERITROPOESE PROERITROBLASTO BASÓFILO Célula progenitora Célula precursora ERITROBLASTO POLICROMATÓFILO ERITROBLASTO ORTOCROMATÓFILO RETICULÓCITO HEMÁCIA Célula madura
ERITROPOESE 1. Volume 2. Picnose 3. Nucléolos 4. Ribossomos 5. Mitocôndrias 6. Expulsão nuclear
Diminuição de hemácias: ANEMIA OU ERITROPENIA • Ferropriva: redução de ferro • Megaloblástica: redução na ingestão de B 12 e B 9 • Perniciosa: redução de B 12 pela degradação no estômago pela falta de fator intrínsico (ex. atrofia da mucosa gástrica) • Aplástica: mal funcionamento da medula óssea • Hereditária ou falcemia: mutação que altera a forma da hemácia (foice).
Aumento de hemácias: POLICITEMIA OU ERITROCITOSE Altitude elevada HB baixa Estimula rins (80%) e fígado (20%) Fluxo sanguíneo baixo. . . Produção de ERITROPOETINA (EPO) Aumenta o amadurecimento de HIPÓXIA eritroblastos em eritrócitos Aumento da oxigenação tecidual
Efeitos Alostéricos PO 2: Hb. O 2 Hb + O 2 Célula (BAIXA AFINIDADE) PO 2: Hb + O 2 Hb. O 2 Alvéolo (ALTA AFINIDADE) Hb + CO Hb. CO (carboxiemoglobina estável) diminui a concentração de Hb. O 2 Efeito Bohr: CO 2 H 2 CO 3 H+ / p. H Logo: Hb. O 2 Hb + O 2 (BAIXA AFINIDADE)
Células brancas/Leucócitos Ocorrência: 4. 000 a 9. 000/mm 3 Redução: Leucopenia ü Incolores e esféricos Aumento: Leucocitose Função: Defesa Imune
Tipos de leucócitos üGranulócitos NEUTRÓFILOS EOSINÓFILOS BASÓFILOS üAgranulócitos LINFÓCITOS MONÓCITOS
CÉLULAS BRANCAS: GRANULÓCITOS - Neutrófilos: 60 -70% - Eosinófilos: 2 -4% - Basófilos: 0, 5 -1%
CÉLULAS BRANCAS NEUTRÓFILOS -Fagócitos ávidos üFUNÇÕES -Defesa imunocelular contra bactérias GR NULOS ESPECÍFICOS • Lisozima → perfura a parede bactérias • Lactoferrina → sequestra Fe 2+ • Síntese de H 2 O 2 e O 2 - (intoxicam bactérias) GRANULÓCITOS
CÉLULAS BRANCAS NEUTRÓFILOS GRANULÓCITOS üPolimorfonucleares: 2 -5 lóbulos ü 9 a 12 µm de diâmetro BASTONETES üGR NULOS: ESPECÍFICOS (colagenase, lactoferrina, lisozima. . . ) AZURÓFILOS (lisossomos com hidrolases ácidas)
Neutrófilos ou polimorfonucleares Corpúsculo de Barr: pequeno apêndice em forma de raquete no núcleo de neutrófilos de mulheres: cromossomo X condensado
CÉLULAS BRANCAS EOSINÓFILOS GRANULÓCITOS üFUNÇÕES -Defesa específica contra antígenos (vírus, vermes e alérgenos) por fagocitose -Fagocita complexos Ag-Ac (Ig. E) -Participa dos processos alérgicos
CÉLULAS BRANCAS EOSINÓFILOS GRANULÓCITOS üPolimorfonuclear: 2 -3 lóbulos ü 12 a 15 µm de diâmetro üMuitos grânulos eosinofílicos ESPECÍFICOS (Internum + Externum) AZURÓFLOS (lisossomos com hidrolases ácidas)
CÉLULAS BRANCAS EOSINÓFILOS GRANULÓCITOS Internum ou Cristalóide GRANULOS ESPECÍFICOS üProteínas básicas (arginina) Externum ou Matrix üEnzimas típicas dos lisossomos Internum Externum
CÉLULAS BRANCAS BASÓFILOS GRANULÓCITOS üNúcleo irregular e retorcido (“S”) üGrânulos específicos intensamente basófilos (HISTAMINA e HEPARINA) üReceptores para Ig. E üFunção: Produção de heparina (anticoagulante) e histamina (vasodilatadora, aumenta a diapedese e participa da formação de edemas)
GRANULOCITOPOESE ü Neutrófilo, eosinófilo e basófilo
CÉLULAS BRANCAS: AGRANULÓCITOS - Linfócitos 20 -30% - Monócitos 3 -8%
CÉLULAS BRANCAS LINFÓCITOS l. DIFERENCIAÇÃO: AGRANULÓCITOS Linfócito B, T, NK e NKT Plasmócitos (Ac), Célula B de memória Célula T auxiliar, Célula T supressora, Célula T citotóxica Célula T de memória NK T Auxiliador (Helper ou T 4): Estimula o B a fazer a diapedese e diferencia-se em plasmócitos, cuja função é a produção de anticorpos. T Citotóxico: Destroem céls parasitadas para que a infecção não se alastre. T Supressor: Inibe o funcionamento dos outro linfócitos, impedindo excessos a partir do momento que o antígeno foi eliminado.
CÉLULAS BRANCAS LINFÓCITOS AGRANULÓCITOS ü 6 a 8 µm de diâmetro üNúcleo esférico e bem corado (grumos grosseiros de cromatina) üCitoplasma escasso e periférico (ribossomos)
CÉLULAS BRANCAS MONÓCITOS Diapedese ü Monócitos Macrófagos (cél. fagocitária e apresentadora de antígenos a céls imunes competentes: linfócitos). üOvais com núcleo reniforme e excêntrico (cromatina frouxa) ü↓RER e ribossomos; ↑CG e Mit. ü 12 a 20 µm de diâmetro AGRANULÓCITOS
CÉLULAS BRANCAS MONÓCITOS AGRANULÓCITOS ü Microvilosidades e vesículas de pinocitose
Tipos de imunização 1. Inata / Não Específica • • Fagocitose de neutrófilos e macrófagos. Resistência da pele. Acidez estomacal. Ação das Killer Cels ou Natural Killer. 2. Adaptativa / Específica (celular e humoral) • • Especificidade. Adaptabilidade. Memória. Reconhecimento do próprio e do não próprio.
Adaptativa ou Específica
A. Celular • Atividade do Linfócitos T citotóxico. • Ativação dos linfócitos B pelos T auxiliadores. B. Humoral • Produção de anticorpos pelos plasmócitos. 3. Ativa (Vacina) Inoculação de antígenos mortos ou atenuados em um indivíduo estimulando a produção de anticorpos. Profilática e duradoura pela geração de memória. 4. Passiva (Soro) Inoculação de anticorpos prontos para combate direto a doença. Temporária.
Hialômero Granulômero PLAQUETAS Feixes de microtúbulos periféricos Grânulos alfa: Fatores de coagulação Grânulos lambda: Lisossomos Grânulos delta: ATP, Ca, 5 -OH
PLAQUETAS üCorpúsculos anucleados de 2 a 4 µm üOcorrência: 400. 000/mm 3 Redução de plaquetas: plaquetopenia ou trombopenia Aumento de plaquetas: plaquetocitose e trombocitose üOrigem: fragmentos de megacariócitos (35 a 100 µm de diâmetro, núcleo lobulado, cromatina grosseira e citoplasma com grânulos)
üFunção: coagulação • Formação de um tampão plaquetário • Ativação do plasminogênio endotelial → FIBRINA • Endotelina: vasoconstrição • Fator de Von Wille Brand: tampão plaquetário • Aumento de ADP: plaquetas grudentas aderem ao colágeno • Remoção do coágulo (plasmina e enz. lisossomais)
PLAQUETAS NA COAGULAÇ O
PLAQUETOPOESE ü MEGACARIÓCITO
Fatores plaquetários Ca ++
Funções: v Preenchimento de cavidades v. Conexão entre os órgãos Tipos: v. Frouxo v. Denso
Frouxo – Poucas fibras fracamente entrelaçadas (abaixo e epitélios)
Denso – Muitas fibras fortemente entrelaçadas v Não modelado: Fibras não orientadas (baço, fígado, testículo) v Modelado: Fibras orientadas (tendão e ligamentos)
Composição Fibras: • Colágenas • Elásticas • Reticulares Substância amorfa v. Líquido Intersticial: Ácido hialurônico v Células:
Células do TCPD • Fibroblastos: Produção de fibras e formação de condrócitos e adipócitos • Adipócitos: Formação do tecido adiposo • Neutrófilos: Fagocitose • Macrófagos: Fagocitose • Plasmócitos: Anticorpos • Mesenquimais: Diferenciação em outras células
v Mastócitos: produção de heparina (anticoagulante) e histamina (vasodilatadora, aumenta a diapedese e participa da formação de edemas) vaso Poro Edemas Líquido Céls DIAPEDESE TCPD Céls Aumento da diapedese
Reação Alérgica
Tecido Adiposo Armazena triglicerídeos. l Isolante térmico. l Proteção contra choques. l Contorno do corpo feminino l l Branca: cél grande com uma única gotícula de gordura (subcutâneo). l Parda: Cél com várias gotículas de gordura. Muitos vasos e mitocôndrias. Produção de calor por oxidação de ác. graxo (R. N. e animais que hibernam).